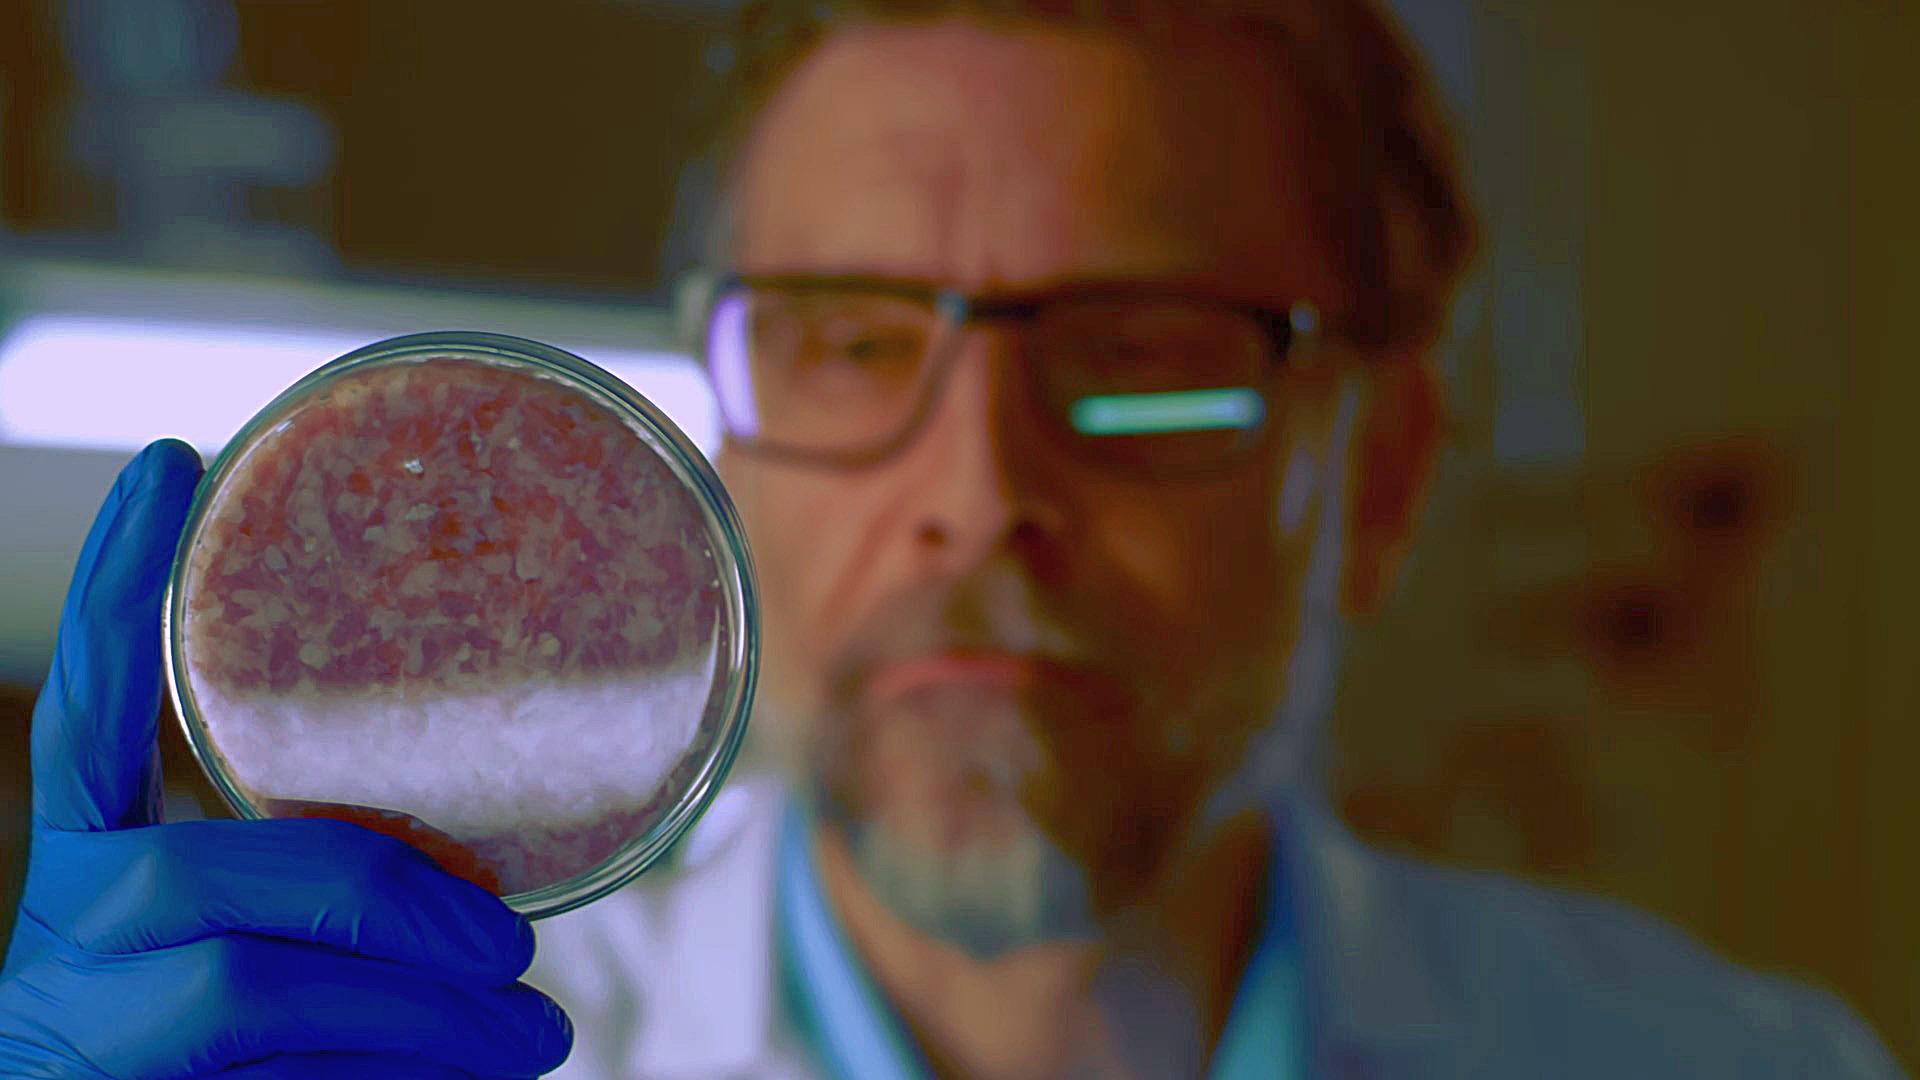

What are some of the biggest challenges facing Fintech Startups in Saudi Arabia?
In 2020, 40% of Fintech Startups in Saudi said that Talent & Recruitment is the most difficult Challenge. Talent & Recruitment is a common challenge for startups around the world.
Other Videos
Saudi fintech is transforming fast—70% cashless transactions by 2023, 216 fintechs in action, and Geidea leading SME-focused payment innovation in the region.
The UAE, Israel and Qatar enjoy political stability, economic prosperity, and social cohesions that rank these states as safer and more secure than the United States on the Fragile States Index.
Egypt, Iran and Algeria are MENA's most populous countries, with a combined population of 230 million.
Fintech adoption around the world has been consistently doubling every two years since 2015, with emerging markets leading the way.
Emerging Markets have been dominating in terms of global fintech adoption, whereas only 3 developed markets are in the top 10
At the end of 2020, there were a total of 87 fintech unicorns globally. 2021 was a fintech breakout year, minting 119 fintechs in the first 9 months of 2021 alone.
Fintechs globally raised $131.5B USD of capital in a single year, posting nearly 150% growth since the last record-high year of 2018.
All four quarters beating any previous years’ quarterly fundraising results and with Q4 being the largest quarter ever reaching $37.8 billion.
Digital Lending was the fastest growing vertical in fintech fundraising. All except two verticals reached triple digit growth that year.
Digital Payments and Currency Exchanges fundraised the most in Saudi Arabia
Register for our free weekly newsletter
Stay up to date with the latest news, special reports, videos, infobytes, and features on the region's most notable entrepreneurial ecosystems
%2Fuploads%2Ffintech%2Fcover3.jpg&w=3840&q=75)